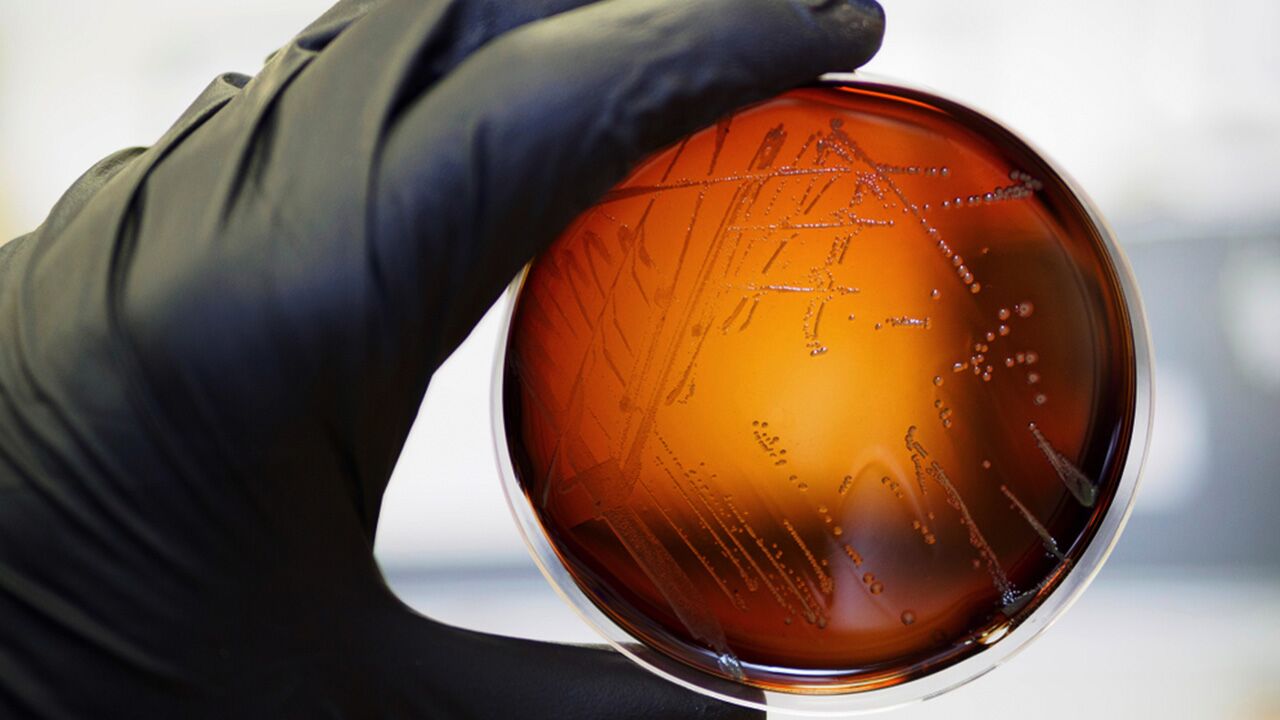

How to Treat Lyme Disease: Your Complete Guide


Lyme disease is a tickborne infectious disease that was first identified in Old Lyme, Connecticut, in 1975. Since that time, the disease has become even more widespread. Once seen primarily in the Northeastern United States, Lyme disease has now been documented in all 50 states and the District of Columbia. While many people who live near wooded areas or grassy spaces are well aware of the dangers of ticks, as the infection has continued to spread, it’s become even more important to know how to treat Lyme disease so as to minimize the risk of potential complications.
What Is Lyme Disease?
The most commonly occurring vector-borne disease in the United States, Lyme disease is caused by the bacteria Borrelia burgdorferi and Borrelia mayonii (Borrelia afzelii and Borrelia garinii are the leading bacterial causes in Europe and Asia). The disease is spread by infected members of the tick species Ixodes scapularis and Ixodes pacificus, commonly known as the black-legged or deer tick.
How Do You Get Lyme Disease?
Anyone bitten by an infected deer tick can contract Lyme disease, but the condition is most likely to affect people who live near or spend time in heavily wooded or grassy areas where the ticks’ preferred hosts—white-footed mice and deer—are most prevalent.
When a tick is looking for a host, it crawls to the top of a blade of grass or bush and holds its front legs up in the air. When a potential meal brushes past, be it animal or human, the tick then grabs hold and searches for a site to feed. However, it doesn’t transmit the bacteria that cause Lyme disease right away. In fact, in most cases, a tick must be attached for 36 to 48 hours before the bacteria are transferred to the host.
Most people are infected with Lyme disease in the spring and summer months after being bitten by an immature tick called a nymph. Because nymphs are extremely small—less than 2 millimeters—they aren’t as easy to see as adult ticks (which are actually more active in cooler weather), and many people don’t notice them.
This is especially true given that ticks tend to search for the nooks and crannies of the body, such as the groin or backs of the knees, or snug areas, such as those covered by a waistband or sock cuff.
What States Have the Highest Rates of Lyme Disease?
As mentioned earlier, Lyme disease has been documented across the United States, but certain areas have higher rates of infection than others. The 10 states with the highest rates of confirmed cases are:
- Maine
- Vermont
- Pennsylvania
- New Hampshire
- Rhode Island
- Delaware
- New Jersey
- Connecticut
- Wisconsin
- Minnesota
Symptoms of Lyme Disease
Known as the great imitator, Lyme disease comes with a host of symptoms that can mimic those of almost any other disease, including multiple sclerosis, chronic fatigue syndrome, fibromyalgia, Alzheimer’s disease, and amyotrophic lateral sclerosis (ALS). Because of the wide range of possible symptoms—and the lack of fully accurate blood tests for diagnosis—some people may remain misdiagnosed for years.
Symptoms of Lyme disease also depend on the stage of infection. One of the first signs that may appear occurs within 3 to 30 days of a tick bite. This is the circular rash known as erythema migrans. This rash appears around the site of the tick bite and slowly expands over the course of several days. As the rash expands away from the site of the bite, the center may become clear, creating a bull’s-eye appearance.
According to the Centers for Disease Control and Prevention (CDC), around 70% to 80% of people who become infected with Lyme disease experience erythema migrans, so people who’ve been in areas where ticks are common should be sure to keep an eye out for this important sign of the infection.
While erythema migrans is typically neither painful nor itchy, it may feel warm and grow to as much as 12 inches across. Early Lyme disease symptoms may also include rashes on other areas of the body as well as flu-like symptoms, such as fever, chills, fatigue, headache, generalized body aches, and swollen lymph nodes.
Weeks or months after initial infection, untreated Lyme disease may then progress to:
Severe headaches | Neck stiffness |
Migrating joint pain and swelling | Irregular heartbeat |
Bell’s palsy (drooping on one side of the face) | Shortness of breath |
Tingling or numbness in the extremities | Dizziness |
Impaired muscle movement | Memory problems |
Because Lyme disease can persist in the body for years without treatment, leading to arthritis and nervous system disorders, it’s important to see your health care provider at the first sign of any of the above symptoms.
Diagnosing Lyme Disease
If you’re one of the majority of people who develop the Lyme disease rash, count yourself among the lucky, as the presence of erythema migrans makes the diagnosis of Lyme disease much simpler. But if you’re one of the 20% to 30% or so of people who don’t develop the rash, your health care provider will need to speak with you about your medical history, including any potential contact with ticks, and perform a physical exam.
As we discussed, laboratory tests for Lyme disease aren’t always exact, so providing your doctor with a detailed account of your symptoms is the most reliable method of diagnosis. However, after your body has begun to make antibodies against the bacteria—which usually takes several weeks after the initial infection—blood tests do become more reliable. The tests recommended by the CDC include:
- Enzyme-linked immunosorbent assay (ELISA) test: This is the test used most often to detect the bacteria that cause Lyme disease. Because it sometimes comes back with false-positive results, it’s not used as the sole method of diagnosis.
- Western blot test: In cases where the ELISA comes back positive, the Western blot is usually used to confirm the diagnosis by detecting antibodies to several B. burgdorferi proteins.
- Polymerase chain reaction (PCR): If you develop neurologic symptoms or swollen joints, a PCR may be performed as well. This test is used to detect the DNA of the Lyme disease bacteria and is conducted through the use of a spinal tap or removal of synovial fluid from an affected joint.
How to Treat Lyme Disease
Treatment of Lyme disease involves the use of oral antibiotics. If caught in the early stages, a 14- to 21-day course of antibiotic therapy is usually quite successful in eradicating the infection, and most people generally recover rapidly and completely. However, if the disease has affected the nervous system or heart, your health care provider may recommend treatment with a 14- to 28-day course of intravenous antibiotics instead.
Unfortunately, not everyone achieves a complete recovery with antibiotic therapy. Even after treatment, some people continue to experience symptoms such as fatigue and muscle and joint pain. When this happens, the condition is known as post-treatment Lyme disease syndrome (PTLDS) or post–Lyme disease syndrome (PLDS) and is not helped by further antibiotic treatment.
The term “chronic Lyme disease” is also sometimes used to describe people who have long-term side effects attributed to infection with Lyme disease. However, because the term has been used to describe people with both confirmed and unsubstantiated cases of Lyme disease, most experts don’t support its use.
In any case, the response to Lyme disease treatment varies from person to person, and while the cause of long-lasting symptoms in patients who’ve been treated with antibiotics is unclear, some experts believe that certain people develop an autoimmune response to the infection that contributes to their symptoms.
Diet and Nutrition
Although antibiotics are the treatment of choice for Lyme disease, there are several steps you can take to support your immune system, minimize symptoms, and reduce inflammation.
One of the most important of these is ensuring you’re supporting your health by eating a diet rich in antioxidants, vitamins, minerals, omega-3 fatty acids, and probiotics. Reducing stress and making sure you’re getting plenty of rest and the appropriate amount of amino acids each day are also essential for supporting your body as it attempts to heal from Lyme disease.
Amino acids, also known as the building blocks of protein, play a key role in almost all biological processes. In fact, a lack of these vital nutrients can lead to a number of health conditions, including hormonal imbalance, muscle loss, weakened immune system response, fatigue, anxiety, and depression.
And like most things, amino acids work best when they’re in balance, so be sure to seek out a formula that not only emphasizes the condition you’re trying to address but also contains a balanced mixture of all nine essential amino acids—the amino acids our bodies can’t make on their own and must obtain from food or supplements.
Lyme Disease Prevention
The best way to treat Lyme disease is to avoid it in the first place. So when enjoying the great outdoors, take these steps to lower your risk of contracting the infection:
- Use insect repellent. Spraying the skin with an insect repellent containing a minimum of 20% DEET has been proven effective in repelling ticks. However, DEET can be toxic to humans as well as ticks, so many people prefer to use natural alternatives. To that end, the CDC lists several essential oils that are also effective in repelling ticks, among them garlic, rosemary, lemongrass, thyme, and geraniol.
- Cover your skin. When walking, camping, or hiking in areas where ticks thrive, wear long pants tucked into socks, shirts with long sleeves, a hat, and even gloves. And if you’re hiking, try to stick to the trail and avoid veering off into tall grass or shrubs.
- Inspect yourself. After spending any time outdoors, inspect every inch of your body (and your pets). Because deer tick nymphs may be no larger than the head of a pin, take your time with this. It’s also a good idea to take a shower after being outside, as ticks can wander around on you and your clothes for hours before settling down to feed.
- Clean up outside. Keeping your yard mowed, leaves raked, and brush cleared around your house can help cut down on tick habitat. Stacking wood in sunny locations also helps discourage the rodents ticks prefer as their hosts.
- Properly remove ticks. If you do spot a tick on your skin and it’s already latched on, use tweezers to gently remove it near its mouth. To avoid leaving mouthparts behind, pull steadily while avoiding squeezing the tick, and then apply antiseptic to the area. However, if mouthparts are left in the skin, make sure to remove them as well before applying antiseptic.
Though Lyme disease is the most common vector-borne disease in the United States, it remains a frustratingly difficult disease to pin down, with even medical societies divided in their evaluation of the infection.
For instance, the Infectious Diseases Society of America (IDSA) describes Lyme disease as “hard to catch and easy to cure” with a short course of antibiotics and denies the existence of chronic Lyme disease.
By contrast, the International Lyme and Associated Diseases Society (ILADS) says Lyme disease is often difficult to both diagnose and treat and may result in persistent symptoms.
And in contrast to IDSA’s belief that a short course of antibiotics is sufficient to eradicate Lyme disease infection, ILADS instead recommends individualized treatment based on factors including symptom severity and treatment response.
As you can see, we still have a long way to go before we fully understand the complexities of Lyme disease, but if we’re educated about what causes the disease and keep a sharp eye out for ticks and typical symptoms of infection, we have a much better chance of beating the infection before long-term complications result.

Up to 25% off Amino
Shop NowTAGS: conditions
Join the Community
Comments (0)
Most Craveable Recipes